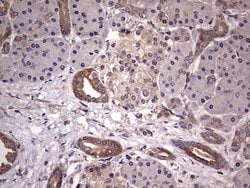
KYNU Monoclonal Antibody (OTI1H1), TrueMAB , OriGene 100 &mu;L | Buy Online | Origene Technologies | Fisher Scientific

missing translation for 'onlineSavingsMsg'
Learn More
Learn More
KYNU Monoclonal Antibody (OTI1H1), TrueMAB™, OriGene

Descripción
Kynureninase is a pyridoxal-5′-phosphate (pyridoxal-P) dependent enzyme that catalyzes the cleavage of L-kynurenine and L-3-hydroxykynurenine into anthranilic and 3-hydroxyanthranilic acids, respectively. Kynureninase is involved in the biosynthesis of NAD cofactors from tryptophan through the kynurenine pathway.Kynureninase is a pyridoxal-5′-phosphate (pyridoxal-P) dependent enzyme that catalyzes the cleavage of L-kynurenine and L-3-hydroxykynurenine into anthranilic and 3-hydroxyanthranilic acids, respectively. Kynureninase is involved in the biosynthesis of NAD cofactors from tryptophan through the kynurenine pathway. Two transcript variants encoding different isoforms have been found for this gene.Kynureninase is a pyridoxal-5′-phosphate (pyridoxal-P) dependent enzyme that catalyzes the cleavage of L-kynurenine and L-3-hydroxykynurenine into anthranilic and 3-hydroxyanthranilic acids, respectively. Kynureninase is involved in the biosynthesis of NAD cofactors from tryptophan through the kynurenine pathway. Two transcript variants encoding different isoforms have been found for this gene.
Especificaciones
Especificaciones
| Antígeno | KYNU |
| Aplicaciones | Immunohistochemistry (Paraffin) |
| Clasificación | Monoclonal |
| Clon | OTI1H1 |
| Concentración | 1 mg/mL |
| Conjugado | Unconjugated |
| Formulación | PBS with 1% BSA, 50% glycerol and 0.02% sodium azide |
| génica | KYNU |
| N.º de referencia del gen | Q16719 |
| Alias de gen | KYNUU, VCRL2 |
| Mostrar más |
Título del producto
Al hacer clic en Enviar, acepta que Fisher Scientific se ponga en contacto con usted en relación con los comentarios que ha proporcionado en este formulario. No compartiremos su información para ningún otro fin. Toda la información de contacto proporcionada se mantendrá de acuerdo con nuestra Política de Privacidad. Política de privacidad.
¿Detecta una oportunidad de mejora?